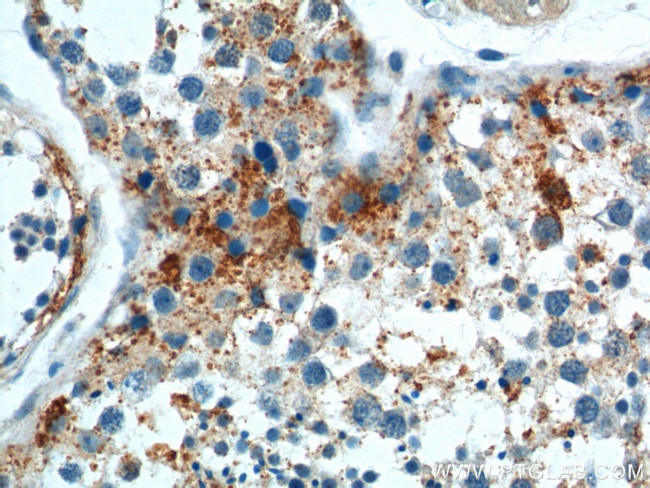
SOHLH1 Antibody in Immunohistochemistry (Paraffin) (IHC (P))
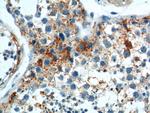
SOHLH1 Antibody in Immunohistochemistry (Paraffin) (IHC (P))

Search
Proteintech
SOHLH1 Polyclonal Antibody
{{$productOrderCtrl.translations['antibody.pdp.commerceCard.promotion.promotions']}}
{{$productOrderCtrl.translations['antibody.pdp.commerceCard.promotion.viewpromo']}}
{{$productOrderCtrl.translations['antibody.pdp.commerceCard.promotion.promocode']}}: {{promo.promoCode}} {{promo.promoTitle}} {{promo.promoDescription}}. {{$productOrderCtrl.translations['antibody.pdp.commerceCard.promotion.learnmore']}}
产品信息
17753-1-AP
种属反应
宿主/亚型
分类
类型
抗原
偶联物
形式
浓度
规格
纯化类型
保存液
内含物
保存条件
运输条件
产品详细信息
Immunogen sequence: MASRCSEPY PEVSRIPTVR GCNGSLSGAL SCCEDSAQGS GPPKAPTVAE GPSSCLRRNV ISERERRKRM SLSCERLRAL LPQFDGRRED MASVLEMSVQ FLRLASALGP SQEQHAILAS SKEMWHSLQE DVLQLTLSSQ IQAGVPDPGT GASSGTRTPD VKAFLESPWS LDPASASPEP VPHILASSRQ WDPASCTSLG TDKCEALLGL CQVRGGLPPF SEPSSLVPWP PGRSLPKAVR PPLSWPPFSQ QQTLPVMSGE ALGWLGQAGS LAMGAAPLGE PAKEDPMLAQ EAGSALGSDV DDGTSFLLTA GPSSWPGEWG PGFRAGPPA (1-328 aa encoded by BC031861 )
靶标信息
Probable transcription factor required during spermatogenesis and oogenesis.
仅用于科研。不用于诊断过程。未经明确授权不得转售。
生物信息学
蛋白别名: newborn ovary helix loop helix; NOHLH; RP11-100C15.3; spermatogenesis associated 27; Spermatogenesis- and oogenesis-specific basic helix-loop-helix-containing protein 1
基因别名: bA100C15.3; bHLHe80; C9orf157; NOHLH; ODG5; SOHLH1; SPATA27; SPGF32; TEB2
UniProt ID: (Human) Q5JUK2
Entrez Gene ID: (Human) 402381